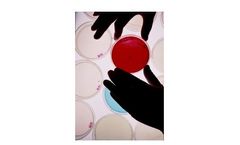
Biofilm Sensor for Legionella Prevention

- Home
- Applications
- paraguay
- laboratory analyzer
Laboratory Analyzer Product Applications Available In Paraguay
ByChromatotec based in Saint-André de Cubzac, FRANCE
ByEnviro Solutions Technology Co.,Ltd based in Wuhan, CHINA
ByAMETEK Spectro Scientific based in Chelmsford, MASSACHUSETTS (USA)
ByGasmet Technologies - a Nederman company based in Vantaa, FINLAND
ByKurita Water Industries Ltd based in Tokyo, JAPAN
ByLRE Medical based in Noerdlingen, GERMANY
ByLumex Instruments based in Mission, BRITISH COLUMBIA (CANADA)
ByCubic Instruments (Wuhan) Ltd. based in Wuhan, CHINA
ByMedica Corporation based in Bedford, MASSACHUSETTS (USA)
ByAMETEK Brookfield based in Middleboro, MASSACHUSETTS (USA)
ByVibraScreener Inc. based in Charlotte, NORTH CAROLINA (USA)
ByEfficiency Scientific Instrument Co., Ltd (ESI) based in SuZhou City, CHINA
ByHeltschl Medizintechnik GmbH based in Schlüsslberg, AUSTRIA
ByElvatech Ltd. based in Kyiv, UKRAINE
ByMolGen based in Veenendaal, NETHERLANDS
ByXenemetrix Ltd. based in Migdal Haemek, ISRAEL
ByRapid Micro Biosystems, Inc. based in Lowell, MASSACHUSETTS (USA)
ByAlvim Srl based in Genova, ITALY
ByElvatech Ltd. based in Kyiv, UKRAINE
ByPluton Biosciences, Inc. based in St. Louis, MISSOURI (USA)